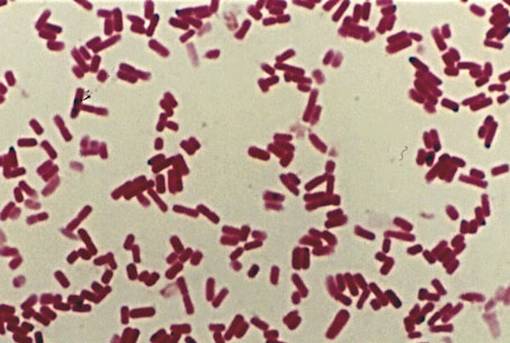

| CATEGORII DOCUMENTE |
| Alimentatie nutritie | Asistenta sociala | Cosmetica frumusete | Logopedie | Retete culinare | Sport |
Clostridium botulinum
Clostridium botulinium face parte din genul Genul Clostridium (gr.closter=fus),Familia Bacillaceae,Ordinul Clostridiales,Clasa Clostridia .
Genul cuprinde peste 180 de specii care din punct de vedere al pataogenitatii se clasifica astfel :
Specii predominant sau exclusive toxigene:
Cl.tetani
Cl.botulinum
Specii toxigene si virulente(agentii gangrenei gazoase)
Cl.chauvoei
Cl.septicum
Cl.perfringens
Cl.novyi
Specii ocazional patogene:
Cl.histolyticum
Cl.sordellii
Cl.bifermentans etc.
Specii nepatogene:
CLOSTRIDIUM TETANI
Este un bacil lung si subtire(0.5-1.7/2-18μ) Gram pozitiv(in culturile vechi se poate decolora foarte usor), mobil cu cili dispusi peritrih,necaspulogeni,sporogeni.Sporul este dispus terminal,cu diametrul mai mare decat celula vegetative,confernd bacteriei aspect de ac de gamalie sau o racheta de tenis.

CLOSTRIDIUM CHAUVOEI
Este un bacil lung(0.5-1.7/1.6-9μ),Gram pozitiv,mobil cu cili dispusi peritrih,necapsulogeni,sporogeni.Sporul este dispus cel mai frecvent central,cu diametrul mai mare decat cel la vegetative,conferind bacteriei aspect de lamiae,sau subterminal,cand bacteria impreuna cu sporul capata aspect de sticla de lampa de petrol.Bacilii sunt dispusi izolat,in perechi sau lanturi scurte.

CLOSTRIDIUM SEPTICUM
Este un bacil lung si gros(0.6-2/1.9-35μ motiv pentru care este considerata cea mai mare bacterie patogena),se dispune in grupari diplo si lanturi scurte,Gram pozitiv,mobil cu cili dispusi peritrih,necapsulogeni,sporogeni.Sporul este dispus cel mai frecvent subterminal cu diametrul mai mare decat celula vegetativa,conferind bacteriei aspect de sticla de lampa de petrol,sau central-situatie cand bacteria capata aspect de lamaie.
CLOSTRIDIUM PERFRINGENS
Este un bacil scurt si gros(1-1.3/3-9μ),cu extremitatile usor rotunjite,Gram pozitiv imobil,capsulogen,sporogen.Sporul este dispus central sau subterminal cu deformarea celulei vegetative.
Sinteza capsulei are loc numai cand bacteria ajunge in organismul animalelor receptive.Capsula nu poate fi evidentiata prin metode de colorare speciale pentru capsula,pentru evidentierea ei folosindu-se la o metoda Casares Gill.
CLOSTRIDIUM NOVYI
Este un bacil mare(unul dintre cei mai mari anaerobi),cu capete rotunjite(0.5-1.4/1.6-22μ),Gram pozitiv mobil cu cili dispusi peritrih,necapsulogeni,sporogeni.Sporul este oval dispus subterminal sau central si deformeaza celula vegetativa.Este dispus izolat sau in lanturi.

CLOSTRIDIUM BOTULINUM
Clostridium botulinum este o bacterie strict anaeroba, Gram pozitiva sporogena,larg raspandita in natura,unde se gaseste sub forma de spori(sol,apa,sedimente marine,resturi vegetale in descompunere etc.),iar prin intermediul prafului,fragmentelor de pamant,ale apei,si resturile vegetale poate ajunge usor in tubul digestiv al omului si animalelor sau in furaje si alimente,unde se poate multiplica.In cursul multiplicarii sale bacteria elaboreaza o exotoxina responsabila de aparitia botulismului.Pe baza structurii antigenice au fost descrise pana in prezent 7 tipuri de toxine botulinice,desemnate cu litere mari ale alfabetului latin,de la A la G.
Intoxicatia botulinica a fost descrisa la om si la numeroase specii de mamifere si pasari(cabaline,bovine,pasari salbatice si domestice),precum si la unele specii de pesti.La om, botulismul este determinat in mod obisnuit de toxinele A,B,E si in mod exceptional de toxinele C si F,in timp ce la celalte specii animalele se realizeaza prin interventia toxinelor C si D,si rareori sub actiunea toxinelor A,B,E.
In conditii naturale, botulismul apare la om fie in urma consumului de produse alimentare in care bacteria s-a multiplicat si a sintetizat toxina,fie in urma multiplicarii bacteriei la nivelul tubului digestive cu producerea "in situ" a toxinei botulinice sau a contaminarii plagilor cu spori de Clostridium botulinum care dupa terminare dau nastere la forme vegetative care vor sintetiza toxina botulinica.

ISTORICUL DESCOPERII C.BOTULINUM
Botulsimul ca imbolnavire,a fost cunoscut inca din sec XVII dar primele date concrete au fost furnizate in perioada 1815-1828 de catre Justimus Kerher,a semnalat 243 de cazuri de botulism la om cu 110 morti aparute in urma consumului de carnati preparati cu sange si ficat.Abea in perioada 1895-1897, Van Ermengen a reusit sa izoleze toxina dintr-o sunca preparata in gospodarie,aliment care a stat la originea unui episod extins de botulism aparut in localitatea Ellezeles,din Belgia.
Tulpina de toxina izolata din splina unei victime a fost inoculta la animalele de experienta la care sa reprodus boala.
Primele investigatii acestei imbolnaviri au fost realizate in Europa,unde ea aparea ca episoade in urma consumului de carnati si in urma carora a fost denumita botulism de la care cuvantul latin "botulus"care inseamna carnat.In Germania denumirea acestei boli este "Wuestvergiftung",denumire care a fost utilizata pentru prima data de catre Van Ermengen.
In perioada 1926-1927,toxina capata o extindere mare in America de Nord unde in acest interval de timp au fost semnalate 162 de focare.

Ulterior au aparut numeroase lucrari stiintifice care semnalau aparitia unor episoade de botulism in diferite zone ale globului,sursele de imbolnavire fiind reprezentate de : conserve de peste,pateuri de ficat etc.
Anul 1976 este considerat foarte important pentru istoricul botulismului deoarece apare pentru prima oara toxina la 2 copii care a avut o evolutie asemanatoare unei boli infectioase,generate de multiplicarea bacteriei in tubul digestive al copiilor unde a ajuns sub forma de spori.

MORFOLOGIA SPECIEI CLOSTRIDIUM BOTULINUM
Este un bacil mare(0.5-2.4/2-22μ),drept sau usor incurbat,Gram pozitiv,mobil cu cili dispusi peritrih,necapsulogeni,sporogeni.Este sporogen,dupa formare sporul este oval,situate subterminal,are dimensiuni mai mare decat diametrul transversal al celulei pe care o deformeaza,dandu-i aspectul de sticla de lampa.La tulpinile de C.botulinum care apartine tipului G,celulele vegetative au dimensiuni mai mari, in timp ce la tulpinile care apartinand tulpinilor B si F, celulele vegetative au dimensiuni mai mici.
Conditii de cultivare si caractere culturale:
Este strict anaerob,se dezvolta bine pe medii uzuale pentru anaerobi.Temperatura optima de dezvoltare este de 25C.
Caractere culturale:
In medii lichide pentru anaerobi(ex. Bullion VF) cultura prezinta turbiditate abundenta, cu depozit omgenizabil si degaja un miros ranced.
Pe suprafata mediilor solide (ex. Agar VF) cand incubarea se efectueaza in conditii de anaerobioza - formeaza colinii de 3-4mmØ, cu margini neregulate, de culoare gri,rizoide.
In profunzimea mediilor solide (ex.Geloza Veillon),formeaza colonii mari globuloase,laxe,cu aspect de puf de papadie.

Majoritatea speciilor Genului Clostridium sunt anaerobe stricte si putine sunt aerotolerante.Unele specii se pot multiplica in prezenta unor cantitati reduse de oxgen atmosferic,dar in aceste conditii nu sporuleaza.Sunt catalaza si oxidaza negative.Se pot multiplica in limite largi de temperatura cuprinse intre 15-69ºC si la pH cuprins intre 4-10.
Sunt prezenti in intestinal vertebratelor si nevertebratelor,unde intervin in procesul de digestie,respective la descompunerea materiilor organice de origine animala sau vegetala.Odata ce materiile fecale ajung in mediul ambient,contaminda solul apele si plantele,unde supravietuiesc timp indelungat,datorita sporilor.
Un numar limitat de specii sunt patogene pentru om si alte specii animale,la care determina boli caracteristice.Patogenitatea poate fi datorata exclusiv toxicitatii sau atat virulentei.Majoritatea speciilor sunt nepatogene.
PROPRIETATI BIOCHIMICE ALE C.BOTULINUM
Este hemolitic si manifesta activitate gelatinolitica si lecitinazica.Nu produce indol.Toate tulpinile fermenteaza glucoza,fructoza,zaharoza si maltoza,insa nu fermenteaza lactoza.
PROPRIETATI ANTIGENICE ALE C.BOTLINUM
Bacilul botulinic poseda antigene celulare O si H(fara importanta practica),exoenzime
proteolitice,lecitinza,hemolizina,dar invazivitatea lui in oraganism este cel mai adesea nula.Infectia se produce foarte rar prin plaga contaminta,prin reactii de seroaglutinare si seroneutralizare,sau identificat 7 biotipuri toxicene.
Pe baza caracterelor metabolice au fost impartite in 4 grupe:
-grupa I,care include tipul A si tulipnile proteolitice ale tipurilor B si F
-grupa a II-a,cu tipul F si tulpinile glucidolitice ale tipurilor B si F
-grupa a III-a,cu tipurile C si D
-grupa a IV-a,cu tipul G
Sensibilitate fata de factorii de mediu
Sporii manifesta o rezistenta crescuta fata de caldura si uscaciune la 100ºC rezista 6 ore,iar la 102ºC timp de 10 minute.
Fata de antibiotice,bacteria prezinta o sensibilitate crescuta.Tulpilnile de C.Botulinum care apartin grupei II si III sunt sensibile fata de penicilina, cefaloxitina si metronidazol,si rezistente fata de gentamicina si acid naldixic.Cele care apartin grupei II sunt sensibile la penicilina,cloramfenicol,tetraciclina,metronidazol si rifampicina.
Razele gamma, asociate cu UV au efect sporicid intens,motiv pentru care radapertizarea reprezinta cea mai eficienta metoda de sterilizare a conservelor si semiconservelor.
PATOGENITATEA:
Toxina botulinica reprezinta unicul factor de patogenitate al germenului si impreuna cu toxina tetanica sunt cele mai puternice toxine naturale.Este singura toxina bacteriana active per os cat si perenteral,bacteria nu se multiplica in organism.
Botulismul este o intoxicatie instalata in urma consumului de alimente sau furaje(pastrate in conditii necorespunzatoare),in care sa multiplicat C.botulinum si a elaborat toxina.Silzoul poate reprezenta un mediu prielnic pentru multiplicarea bacteriei,motiv pentru care acesta nu se administreaza la cabaline.
Cand toxina se sintetizeaza concomitent cu multiplicarea bacteriei,la temperaturi optime de 25-30ºC,in conditii de anerobioza.In culturi toxina este evidentiabila in a 5-9 zi,atingand un nivel maxim de 11-13 zile.
Toxina botulinica este o exotoxina de natura proteica,termolabila(este distrusa in 5 minute la 80ºC,iar in conserve in 20 de minute la 100ºC).Ea este inactivata de solutia Lgol,de permangat de potasiu si de alcool.
Toxina se absoarbe pe cale digestiva si actioneaza prin inhibarea contractiei musculare datorita blocarii activitatii acetilcolinei la nivelul placilor neuromusculare,determinand paralizii de tip flasc.
In functie de modalitatea in care apare boala la om perioda de incubatie variaza intre 5 ore si 10 zile(in medie aceasta este cuprinsa intre 12-60 ore).Simptomele debuteaza prin tulburari oculare(defecte de acomodare,aboliere a reflexului fotomotor,midriaza,ptoza palpebrala,strabism etc.),urmate de astenie si disfunctii ale sistemului nervos autonom,care se traduc prin uscarea mucoasei bucale,disfonie,dificultati in deglutitie,disurie,atonie intestinala si diaree.In formele grave se produc paralizii de tip flasc ale membrelor si dificulati in respiratie.
Moartea este determinata prin insuficienta respiratore,datorata paraliziei diafragmului si muschilor intercostali.
Procentul de mortalitate variaza in functie de cantitatea de toxina ingerata si de tipul acesteia(toxinele A si F determina intotdeauna formele cele mai grave).
Toxiinfectia botulinica a fost descrisa atat la copii mai mici de 1 an cat si la adulti.Principala sursa de contaminare in toxiinfectia botulinica a copilului este reprezentata de consumul de miere de albine sau de siropuri preparate din miere.In SUA,botulismul este foarte frecvent(1444 de cazuri au fost descrise in 1973 si 1996) si afecteaza in varsta de 15 zile pana la 6 luni.Cazuri sporadice de botulism infantil au fost descrise si in Argentia, Australia,Brazilia,Canada,Anglia,Ceho-Slovacia,Franta,Italia,Japonia si Suedia.
Desi apare sporadic in ultimii ani a fost descris la toxicomanii care utilizeaza pentru inocularea drogurilor, seringi sau chiar droguri contaminate cu spori de C botulinum.
In anul 2002 au fost raportate in Anglia 16 cazuri de botulism,aparute ca urmare a inocularii intravenoase de droguri,iar in Norvegia,in perioada 1997-2000,4 cazuri.
La animale botulsimul apare mai ales atunci cand consuma furaje in care se gaseste deja sintetizata toxina sau cand acestea traiesc in medii puternic contaminate cu spori de C.Botulinum.Unele animale cum ar fi suinele, sau pisica pot fi purtatoare clinic sanatoase de C.Botulinum,in aceste cazuri putand dezvolta sporadic imbolnaviri spontane.Mai frecvent botulismul a fost descris la unele specii de pasari salbatice sau domestice,prin interventia tulpinilor de tip B,C si E.La bovine ei ecvine boala poate fi determinata de tulpini de C.Botulinum apartinand tipurilor A,B,C si D cu predominanta tipurile C si D.
Unele specii de pesti sunt sensibile la botulism(mai ales prin ingerarea de produse contaminate cu toxina E).In Europa au fost descrise cazuri de botulism la pastravi,iar in SUA la somon.
La animale indiferent de specie botulismul apare dupa o perioada de incubatie intre 8-36 ore iar tabloul clinic variaza in limite foarte largi.In formele benigne animalele bolnave exprima o usoara paralizie a muschilor motori si refuza sa se deplaseze.In formele grave se constata semen de paralizie flasca,initial la musculatura trenului posterior,apoi la musculatura membrelor anterioare.Reflexele si tonusul muscular sunt diminuate sau absente.Se constata apoi paralizia muschilor faciali,disfonie(mai ales la caine,constipatie,retentie urinara,diminuarea secretiei salivare,si lacrimale,midriaza,reducerea reflexelor pupilare si palpebrale.Boala poate evolua fie spre moarte rapida din cauza asfixiei fie spre vindecare progresiva in cateva zile sau in cateva saptamani.
Neurotoxinele botulinice sunt cele mai puternice dintre toate toxinele bacteriene,animale vegetale si compusi chimici cunoscuti pana in prezent.Aceste neurotoxine sunt de 15 mii de ori mai toxice decat aconitina,cel mai toxic alcoid cunoscut.Un milligram de toxina botulinica contine 1.2-3.8X10 la a 6 DLM pe kg corb cobia,aceasta insemnand -dupa Van Heynigen ca 200 gr toxina pura poate omora intreaga populatie a globului.
Nu se cunoaste exact toxica mortala pentru om,dar sa preconizat ca ea este cuprinsa intre 0.1-1μgr(dupa David T.Kingsburi si Gerrard E.W. Wagner).A fost descris un caz de multiplicatie mortala cu toxina la om in urma consumului unei jumatati de maslina.Puterea patogena a toxinelor variaza in functie de specia animala,de calea de administrare,precum si de tulpina C.Botulinum.Calea aparenterala este mai severa decat cea orala.
In urma tratarii toxinelor botulinice cu formol si caldura,aceastea se transforma in anatoxine si pot fi utilizate pentru vaccinarea persoanelor care prin activitatea profesioanala sunt supuse riscului de contaminare a botulismului.Tendinta actuala este aceea de a utiliza compusi recombinati ai toxinele ca vaccin,compusi constituiti din fragmente de toxina cu activitate imunogena,dar lipsiti de activitate toxica.Acel fragment de toxina,obtinut prin inginerie genetica,corespunde domeniului de fixare a toxinei botulinice,pe receptorul sau celular,iar anticorpii rezultati in urma raspunsului imun blocheaza situsul active de pe suprafata celulelor tinta si impiedica astfel fixarea toxinei pe receptorul ei specific de pe membrana celulelor.
Avantajul utilizarii acestui tip de vaccine consta in faptul ca manipularea toxinei recombinate ofera o perfecata securitate operatorilor,intrucat aceastia nu manipuleaza si nu utilizeaza toxina activa,riscul de intoxicare fiind complet eliminate.Dozele terapeutice necesare pentru tratamentul botulismului la om variaza de la 60-100ml iar in cazuri grav se pot administra 500-700ml ser antibotulinic.Cu cat se intervine mai repede la aparitia primelor semne de imbolnavire si se practica asocierea cu o terapie adecvata,spalaturi stomacale transfuzie,respiratie artificiala,administrarea de narcotice etc.

TEHNICA IZOLARII SPECIEI DIN PRODUSE ALIMENTARE
Izolarea speciei din produsele alimentare incriminate reuseste rar din cauza ca dupa multiplicarea celulelor vegetative aceasta fie sporureaza,fie majoritatea se autolizeaza.Pentru aceste considerente este necesar ca,inainte de prelucrarea probelor,sa se stabileasca cu multa responsabilitate protocolul de lucru cel mai adecvat,astfel incat,daca bacteria este sigur prezenta in probele recoltate sa poata fi izolata si identificata.
Probele destinate izolaraii acestei bacterii trebuie pastrate la 4ºC pana in momentul prelucrarii lor,cu exceptia celor destinate in cutii nedeschise,care se pot pastra la temperature laboratorului.Probele solide se amesteca in parti egale cu solute tampon fosfat salin,care in prealabil a fost sterilizat prin autoclavare,intr-o punga speciala.
Pentru izolarea bacteriei se folosesc mai multe medii de cultura lichide si solide.Ca medii lichide se foloseste bulionul cu extract de drojdie,glucoza,peptone,tripticaza(TPGY) si bulion cu extract de drojdie,glucoza,peptone,tripsina(TPGYT),iar ca medii solide agarul cu galbenus de ou si ficat de vital,precum agarul cu sange de cal si ficat de vital.Se poate folosi si medii selective,care contin in compozitia lor chimica cicloserina,sulfadiazine,acid naldixic,kanamicina si gentamicina.
In diagnosticul botulismului,se folosesc urmatoarele teste:ELISA,RIA,hemaglutinarea pasiva si PCR,care nu inlocuiesc insa testul pe soarece.

BIBILIOGRAFIE
Microbiologia Medicala Vetereinara -Volumul I,autor:Simona Ivana
Microbiologia Medicala Vetereinara -Volumul II,autor:Simona Ivana
Bacteriologie Veterinara Speciala -Practicum,autori:Dobre Mimi,Simona Ivana,Carmen Negoita si Iulian Togoe

CHIOREAN ANNE-MARI
GRIGORAS ALEXANDRA IOANA
OLOGU FLORINA
SERBAN ECATERINA ANCA
GRUPA 4105
ANUL I CEPA
|
Politica de confidentialitate | Termeni si conditii de utilizare |
Vizualizari: 5085
Importanta: ![]()
Termeni si conditii de utilizare | Contact
© SCRIGROUP 2025 . All rights reserved